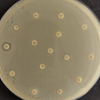
image

Lanche de MC Donald’s causa surto de bactéria intestinal E. coli; entenda
Autoridades sanitárias americanas estão investigando o caso. A suspeita é de que as cebolas do lanche, que são servidas cruas, estivessem contaminadas.

No início desta semana (22/10), o Centro de Controle e Prevenção de Doenças dos EUA (CDC, na sigla em inglês) emitiu um alerta de segurança alimentar após um surto da bactéria E. coli ser registrado em vários lugares dos Estados Unidos, relacionado ao hambúrguer Quarter Pounder (semelhante ao "Quarteirão", no Brasil) vendido pelo McDonald's.
Segundo o CDC, o número de pessoas infectadas pela bactéria, que eram de 49 quando foi emitido o alerta, subiu para 75 nesta sexta-feira (25). Duas pessoas infectadas desenvolveram uma complicação perigosa de doença renal e uma morreu após contrair a bactéria.
Autoridades sanitárias americanas estão investigando o caso. A suspeita é de que as cebolas do lanche, que são servidas cruas, estivessem contaminadas.
Em nota, o diretor de cadeia de suprimentos do McDonald's na América do Norte, Cesar Piña, afirmou que as primeiras descobertas vincularam as cebolas ao “único fornecedor que atende a três centros de distribuição”. Após o surto ser anunciado, a empresa suspendeu a venda do hambúrguer em vários estados do país.
Após ser anunciado, o surto causou uma queda vertiginosa, de 6%, nas ações do restaurante na Bolsa de Valores dos EUA em negociações após o expediente.
VEJA MAIS:
O que é a E. coli?
A bactéria Escherichia coli (E. coli) é um microrganismo comum que vive no intestino humano e de animais, sendo, na maioria das vezes, inofensiva. No entanto, algumas cepas são altamente perigosas e podem causar graves infecções alimentares.
No caso do McDonald's, o surto foi causado por um tipo específico, a E. coli O157, que produz uma toxina que provoca diarreia perigosa e pode levar à insuficiência renal e outros problemas graves. A possibilidade da bactéria comprometer os rins é o principal alerta e motivo por ela poder causar a morte de quem está contaminado.
A E. coli é geralmente transmitida por alimentos ou água contaminados, como carne mal cozida, leite não pasteurizado e vegetais crus que entraram em contato com fezes infectadas.
(*Beatriz Rodrigues, estagiária sob supervisão da coordenadora de Oliberal.com, Heloá Canali)
Palavras-chave
COMPARTILHE ESSA NOTÍCIA